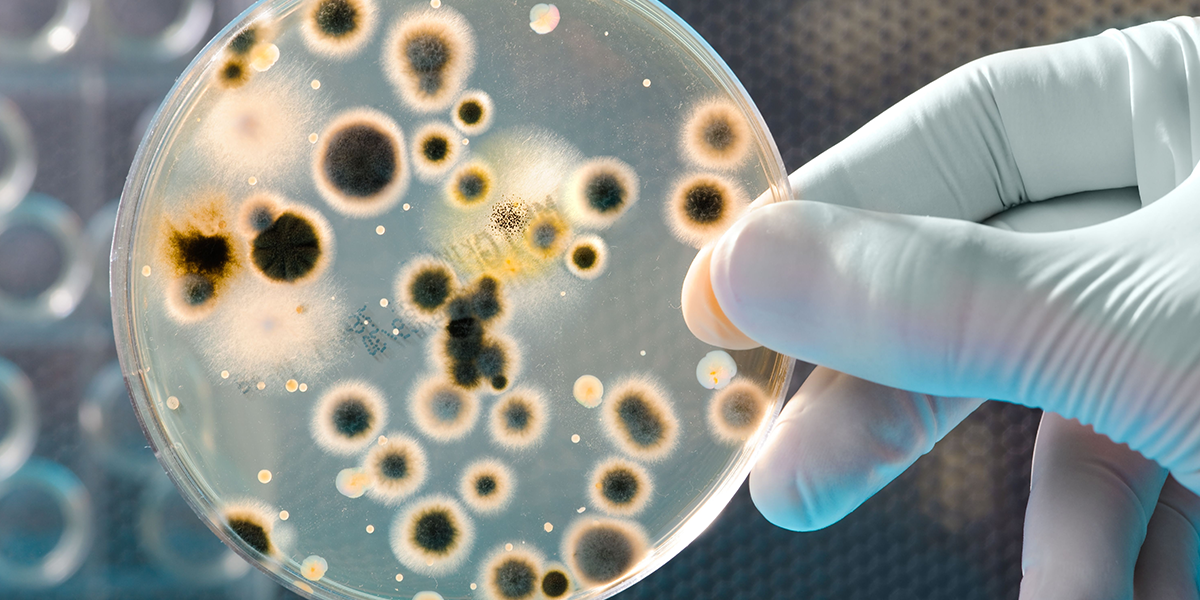
"От Древности до Будущего: Роль Грибов в Нашем Мире"

"От Древности до Будущего: Роль Грибов в Нашем Мире"
Грибы в Нашей Жизни, Жизни Планеты Земля и Даже Вселенной: Малоизвестные Факты
Грибы, эти удивительные создания природы, играют огромную роль в жизни планеты и, возможно, даже за ее пределами. Несмотря на их неприметный вид и скромные размеры, грибы являются неотъемлемой частью экосистем, культурных традиций и научных исследований. От древних рецептов до современных медицинских открытий, от мифов и легенд до передовых технологий — грибы проникли во все сферы нашей жизни.
Эта статья расскажет о малоизвестных фактах, связанных с грибами, и раскроет их значимость в различных аспектах нашей жизни. Вы узнаете, как грибы использовались в древности и какие легенды с ними связаны, какие медицинские свойства они имеют и как влияют на наше здоровье, какие традиционные блюда с грибами популярны в разных культурах, а также о современных технологиях, использующих грибы для производства продуктов. Мы также затронем историческую и культурную роль грибов, обсудим споры и современные исследования, а также этические вопросы, связанные с их использованием.
Погрузитесь в мир грибов и откройте для себя удивительные и малоизвестные факты, которые помогут вам увидеть эти организмы в новом свете.
Историческое Использование Грибов

С древних времен грибы были неотъемлемой частью человеческой культуры. В старинной русской кухне грибы занимали особое место, добавляя глубину вкуса и разнообразие блюдам. Грибы использовались в супах, пирогах, маринадах и других блюдах, причем их ценили не только за вкусовые качества, но и за питательные свойства.
Древние рецепты, дошедшие до нас через века, свидетельствуют о важности грибов в повседневной жизни наших предков. Например, в Древней Руси грибы были важным компонентом постной кухни, когда мясо и рыба были под запретом. Грибы заменяли эти продукты, обогащая рацион полезными веществами и добавляя разнообразие.
Кроме кулинарного применения, грибы играли важную роль в обрядах и церемониях древних культур. Легенды и мифы, связанные с грибами, рассказывают об их мистических свойствах. Шаманы и знахари использовали грибы в своих ритуалах, веря, что они могут связывать миры людей и духов. В древних славянских обрядах грибы часто выступали как символ плодородия и благополучия.
Исторические источники также свидетельствуют о том, что грибы были важным элементом обмена и торговли. В некоторых регионах грибы ценились наравне с другими продуктами питания и даже использовались в качестве валюты. Это подчеркивает их значимость в экономике и социальной жизни древних обществ.
Таким образом, грибы не только питали людей, но и играли важную культурную и духовную роль, оставляя глубокий след в истории и традициях различных народов.
Медицинские Свойства Грибов

Грибы издавна привлекали внимание не только кулинаров, но и целителей. Их уникальные медицинские свойства были известны еще в древности. Одним из наиболее ярких примеров использования грибов в медицине является история князя Владимира Мономаха. По легенде, он исцелился от рака губы благодаря специальному отвару из грибов. Этот случай показывает, что грибы уже тогда рассматривались как мощное лечебное средство.
Современная наука подтверждает, что грибы обладают широким спектром лечебных свойств. Они могут производить антибиотики, противовирусные и противоопухолевые вещества. Самый известный пример — это пенициллин, первый антибиотик, который был выделен из плесневого гриба Penicillium notatum Александром Флемингом в 1928 году. Это открытие перевернуло медицину и спасло миллионы жизней, доказав, что грибы могут быть ключом к борьбе с инфекционными заболеваниями.
Множество видов грибов используется в современной медицине для лечения различных заболеваний. Например, шиитаке, широко применяемый в традиционной японской медицине, известен своими противоопухолевыми и иммуномодулирующими свойствами. Чага, растущая на березах, используется для улучшения общего состояния здоровья и укрепления иммунной системы.
Интересно, что грибы находят применение и в самых неожиданных медицинских контекстах. Например, кожицу дождевиков можно использовать вместо лейкопластыря, так как ее внутренняя часть обладает бактерицидными свойствами. Это свидетельствует о том, что грибы продолжают удивлять и вдохновлять исследователей, открывая новые способы использования своих уникальных свойств.
Таким образом, грибы остаются важным объектом медицинских исследований, предлагая новые возможности для лечения и профилактики заболеваний. Их богатый химический состав и способность производить биологически активные вещества делают их незаменимыми в арсенале современной медицины.
Кулинарные Традиции

Грибы занимают почетное место в кулинарных традициях многих народов, придавая блюдам уникальные вкусовые и ароматические характеристики. В русской кухне грибы издавна считались деликатесом и использовались для приготовления самых разнообразных блюд.
Одним из наиболее известных русских блюд с грибами является многослойный салат, который включает в себя грибы, овощи и мясо, соединенные вместе в гармоничной композиции. Этот салат демонстрирует, как грибы могут улучшить вкусовые качества блюда, добавляя ему богатство текстур и ароматов.
Еще одно традиционное русское блюдо — стерлядь, фаршированная грибами. Стерлядь, фаршированная грибами, является настоящим кулинарным шедевром, который готовится на особые торжества. Грибы в этом блюде используются не только для фаршировки, но и для создания богатого соуса, подчеркивающего нежный вкус рыбы.
В других культурах грибы также играют важную роль. Во Франции грибы часто добавляют в рагу и соусы, придавая им глубину и насыщенность вкуса. Французы особенно ценят трюфели и шампиньоны, которые используются в изысканных блюдах и деликатесах.
Итальянская кухня славится своими пастами и пиццами, в которые грибы добавляют для улучшения вкусовых качеств. Популярные блюда, такие как ризотто с грибами, представляют собой прекрасный пример того, как грибы могут обогатить текстуру и аромат блюда.
В Азии грибы занимают центральное место в таких кухнях, как китайская и японская. Например, в Японии грибы шиитаке и мацутаке используются в супах, тушеных блюдах и на гриле. Их насыщенный вкус и полезные свойства делают их неотъемлемой частью японской диеты.
Таким образом, грибы являются универсальным ингредиентом, который используется в различных кухнях мира. Они не только придают блюдам уникальный вкус и аромат, но и обогащают их питательными веществами, делая их полезными и вкусными. Благодаря своим уникальным свойствам грибы продолжают занимать важное место в кулинарных традициях многих народов, вдохновляя поваров на создание новых кулинарных шедевров.
Современные Технологии и Грибы

Современные технологии использования грибов представляют собой захватывающую область, объединяющую биотехнологии и промышленное производство. Грибы находят применение в самых различных отраслях, от пищевой промышленности до фармацевтики.
Одним из примеров использования грибов в современной технологии является производство лимонной кислоты. Лимонная кислота, широко используемая в пищевой промышленности и фармацевтике, производится с помощью грибов рода Aspergillus. Эти грибы способны эффективно синтезировать лимонную кислоту из сахаров, что делает процесс производства более экономичным и экологически чистым.
Генетически модифицированные дрожжи являются еще одним значительным достижением в области биотехнологий. Они используются для производства различных продуктов, включая сыр, хлеб и алкогольные напитки. Например, с помощью генетической модификации дрожжей ученые смогли улучшить процессы ферментации, что привело к повышению качества и вкусовых характеристик продуктов.
Инновационные разработки также включают использование грибов для создания биоматериалов. Например, компания Ecovative Design создает упаковочные материалы из мицелия грибов. Эти материалы являются биоразлагаемыми и могут заменить пластиковую упаковку, что значительно уменьшает загрязнение окружающей среды.
Грибы также используются в производстве заменителей мяса. Продукты на основе грибов, такие как грибы портобелло и королевские вешенки, стали популярными среди вегетарианцев и веганов благодаря их мясистой текстуре и высокому содержанию белка. Они обеспечивают здоровую и экологически чистую альтернативу животным продуктам.
Кроме того, грибы находят применение в фармацевтике для производства различных лекарственных препаратов. Исследования показывают, что грибы могут быть источником новых антибиотиков и противоопухолевых средств. Например, грибы рода Penicillium используются для производства антибиотиков, а грибы рода Ganoderma — для создания иммуностимулирующих препаратов.
Таким образом, современные технологии использования грибов открывают новые горизонты для науки и промышленности. Грибы становятся ключевым элементом в разработке экологически чистых материалов, улучшении пищевых продуктов и создании эффективных лекарственных средств, что подчеркивает их значимость в современном мире.
Историческая и Культурная Роль Грибов

Грибы играли значительную роль в культурных традициях различных народов на протяжении всей истории. В древних цивилизациях Центральной и Южной Америки грибы часто использовались в религиозных и медицинских обрядах. Например, у ацтеков грибы были известны как "теонанакатль", что переводится как "плоть богов". Эти грибы использовались в ритуалах, чтобы войти в контакт с божествами и получить духовное просветление.
В древней славянской культуре грибы также занимали важное место. Славяне верили, что грибы обладают магическими свойствами и могут приносить удачу и здоровье. Грибы часто использовались в обрядах плодородия и урожая, а также в различных народных сказках и легендах.
Мифы и верования, связанные с грибами, можно найти и в других культурах. В китайской традиционной медицине грибы, такие как рейши и кордицепс, считались эликсирами бессмертия и использовались для улучшения здоровья и долголетия. Эти грибы до сих пор почитаются в Китае и используются в медицинских практиках.
В европейской культуре грибы также имели свое значение. Трюфели и белые грибы считались деликатесами и подавались на столы знати. Они были символом изысканности и богатства. В то же время, в некоторых регионах Европы существовали опасения по поводу употребления определенных видов грибов, что отражалось в местных кулинарных традициях и поверьях.
Таким образом, грибы являются важной частью культурного наследия многих народов, оставляя глубокий след в их мифах, легендах и обрядах.
Споры и Современные Исследования
Современные исследования грибов вызывают множество споров и дискуссий. Одной из главных тем обсуждения является безопасность и эффективность использования грибов в пище и медицине. Генетически модифицированные грибы и дрожжи, используемые в промышленности, вызывают опасения у некоторых ученых и потребителей из-за возможных рисков для здоровья и окружающей среды.
Например, споры ведутся вокруг использования генетически модифицированных дрожжей в производстве продуктов питания. С одной стороны, такие дрожжи могут значительно улучшить качество и устойчивость продуктов. С другой стороны, существуют опасения по поводу долгосрочных последствий их употребления.
В то же время, современные исследования показывают огромный потенциал грибов в различных областях. Исследования продолжают открывать новые виды антибиотиков и противоопухолевых препаратов на основе грибов. Также грибы используются для разработки биотоплива и биоматериалов, что может существенно снизить экологическую нагрузку на планету.
Исследования также показывают, что грибы могут играть важную роль в восстановлении экосистем. Микоризные грибы, например, способствуют росту растений и улучшают здоровье почвы. Это открывает новые возможности для устойчивого сельского хозяйства и лесоводства.
Таким образом, несмотря на споры, исследования грибов продолжают приносить новые открытия и перспективы, предлагая инновационные решения для множества современных проблем.
Будущее и Этические Вопросы

Будущее использования грибов в науке и промышленности связано с множеством этических вопросов. Одним из главных является возможное влияние генетических модификаций на здоровье человека и окружающую среду. Генетически модифицированные организмы (ГМО) вызывают много споров из-за недостаточности долгосрочных данных об их безопасности.
Также возникают вопросы о правах на интеллектуальную собственность и доступности новых технологий. Компании, занимающиеся разработкой и продажей продуктов на основе генетически модифицированных грибов, могут получить монопольное положение, что приведет к ограничению доступа к этим технологиям для мелких производителей и развивающихся стран.
Кроме того, возникает вопрос об ответственности за возможные негативные последствия использования генетически модифицированных грибов. Кто будет нести ответственность в случае возникновения проблем со здоровьем или ущерба для экосистем?
Тем не менее потенциал грибов в решении глобальных проблем, таких как изменение климата, потеря биоразнообразия и обеспечение продовольственной безопасности, делает их важным объектом для дальнейших исследований и разработок. Грибы могут стать ключом к устойчивому развитию и экологически чистым технологиям.
Таким образом, будущее использования грибов требует тщательного рассмотрения этических вопросов и ответственности, чтобы обеспечить их безопасное и эффективное применение на благо человечества и природы.
Заключение
Грибы играют важную роль в нашей жизни, оказывая влияние на культуру, медицину, кулинарию и науку. Уникальные свойства делают их незаменимыми в различных сферах, от древних обрядов до современных технологий. Несмотря на споры и вызовы, связанные с использованием грибов, их потенциал для улучшения жизни человека и состояния окружающей среды неоспорим.
Понимание и ответственное использование грибов могут привести к новым открытиям и инновациям, которые помогут решить многие из стоящих перед нами проблем. Грибы остаются важным объектом для изучения и вдохновения, предлагая нам бесконечные возможности для улучшения нашего мира.